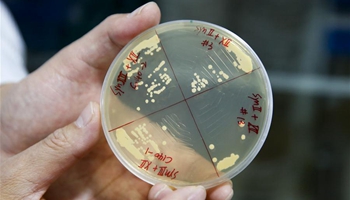

People attend the Tel Aviv Purim Festival street party in downtown Tel Aviv, Israel, on March 10, 2017. Purim is a Jewish holiday that commemorates the deliverance of the Jewish people from Haman's plot during the reign of the ancient Persian Empire, according to the Biblical Book of Esther. (Xinhua/Guo Yu)